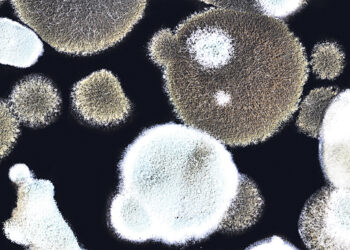
ВОЗ предупреждает  о новых грибковых заболеваниях

Беженцы в Германии: что нужно знать им и их близким
4 марта, 2022
10 заповедей буддизма
25 августа, 2023
EC-карты уходят в прошлое
30 сентября, 2022
Проездные и разовые билеты снова подорожают
26 августа, 2022
ИЗРАИЛЬ ЗАКРЫЛ НЕБО ГЕРМАНИИ
10 декабря, 2025
«Немыслимое» становится реальностью
10 декабря, 2025
ЗНАЛ БЫ ПРИКУП- НЕ ЖИЛ БЫ В СОЧИ…
28 ноября, 2025
Дракон Запад больше жив, чем мертв
28 ноября, 2025